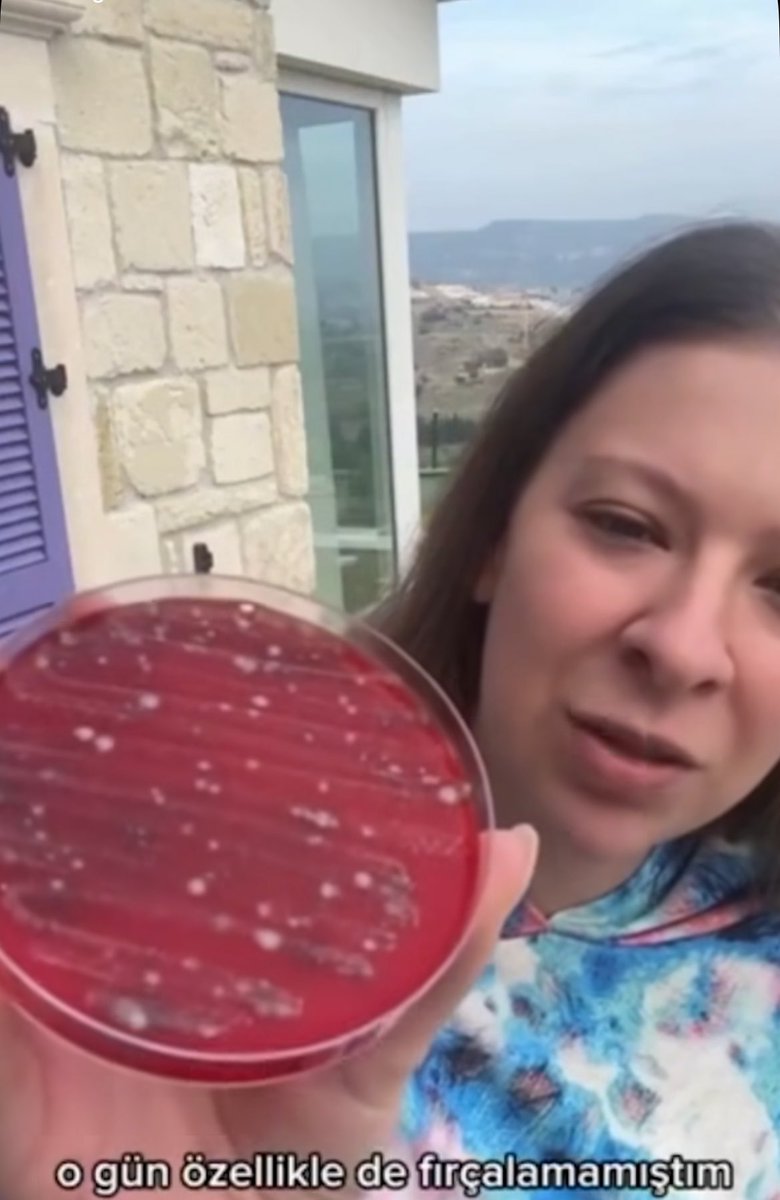
Uzmanı benim gel anlatayım

Kedilerin tükürüğü insanlardan farklı olarak asidik bir pHa sahip bu yüzden zaten bakterilerin yarısını eledik 
Diğer bir kısmını da yine tükürüğün içerisinde bulunan Laktoferrinden eliyoruz (bakterilerin demiri kullanmasını engellediği için

AMC Kittie
@amcturkish
ID: 1819858691493142528
03-08-2024 22:12:11
2,2K Tweet
40 Followers
82 Following



Ankara Patiliköy Sonunda bugün ziyaret edebildim. İstenirse ne kadar güzel şeyler yapılabileceğinin canlı bir örneği. Emeği geçenlere sonsuz teşekkürler. Yardım için maddi durumunuz yoksa bile ziyaret için gidin. Sevilmek için bekleyen canlarla güzel bir gün geçirirsiniz.











Özlem Avcı KEDİLERE MAMA VERMEK YASAKLANMADI SİZ DE YANLIŞ BİLGİ YAYMAYIN SADECE---OKUL ÖNÜNDE HASTANE BAHÇESİNDE "HİJYENE' UYMAMAK ' YASAKLANDI- ***TEMİZ BİR TABAKLA HERYERDE MAMA VEREBİLİRSİNİZ-Kİ --KEDİYE KÖPEĞE YİYECEK VERDİĞİNİZ İÇİN HAPİSE GİRMİYORSUNUZ ***SİZE SADECE ZABITA CEZA


Ankara Patiliköy T.C. İçişleri Bakanlığı T.C. Adalet Bakanlığı TC İstanbul Valiliği İstanbul Emniyet Müdürlüğü @tümyad4 isimli derneğin x hesap kullanıcısı tarafımıza bir yıldır asılsız bir çok paylaşımı ile ilgili suç duyurularımızı yaptık.Beklemedeyiz. Ancak iftira hitamlarında çok ileriye gidiyor. Bu hesabın kullanıcısı S.K isimli kişi ve sayfası ile ilgili gerekli işlemler


Değil 2400 sana 2 milyar yıl ceza verseler gene chpye oy moy yok olm Ekrem İmamoğlu Kemal Kılıçdaroğlunun emir eriyken şimdi başkan olan Özgür Özel senin kemale karşı olduğuna anca senin kitlen inanır, Akepenin aparatısiniz başka bir şey değilsiniz oy moy yok CHP 🇹🇷